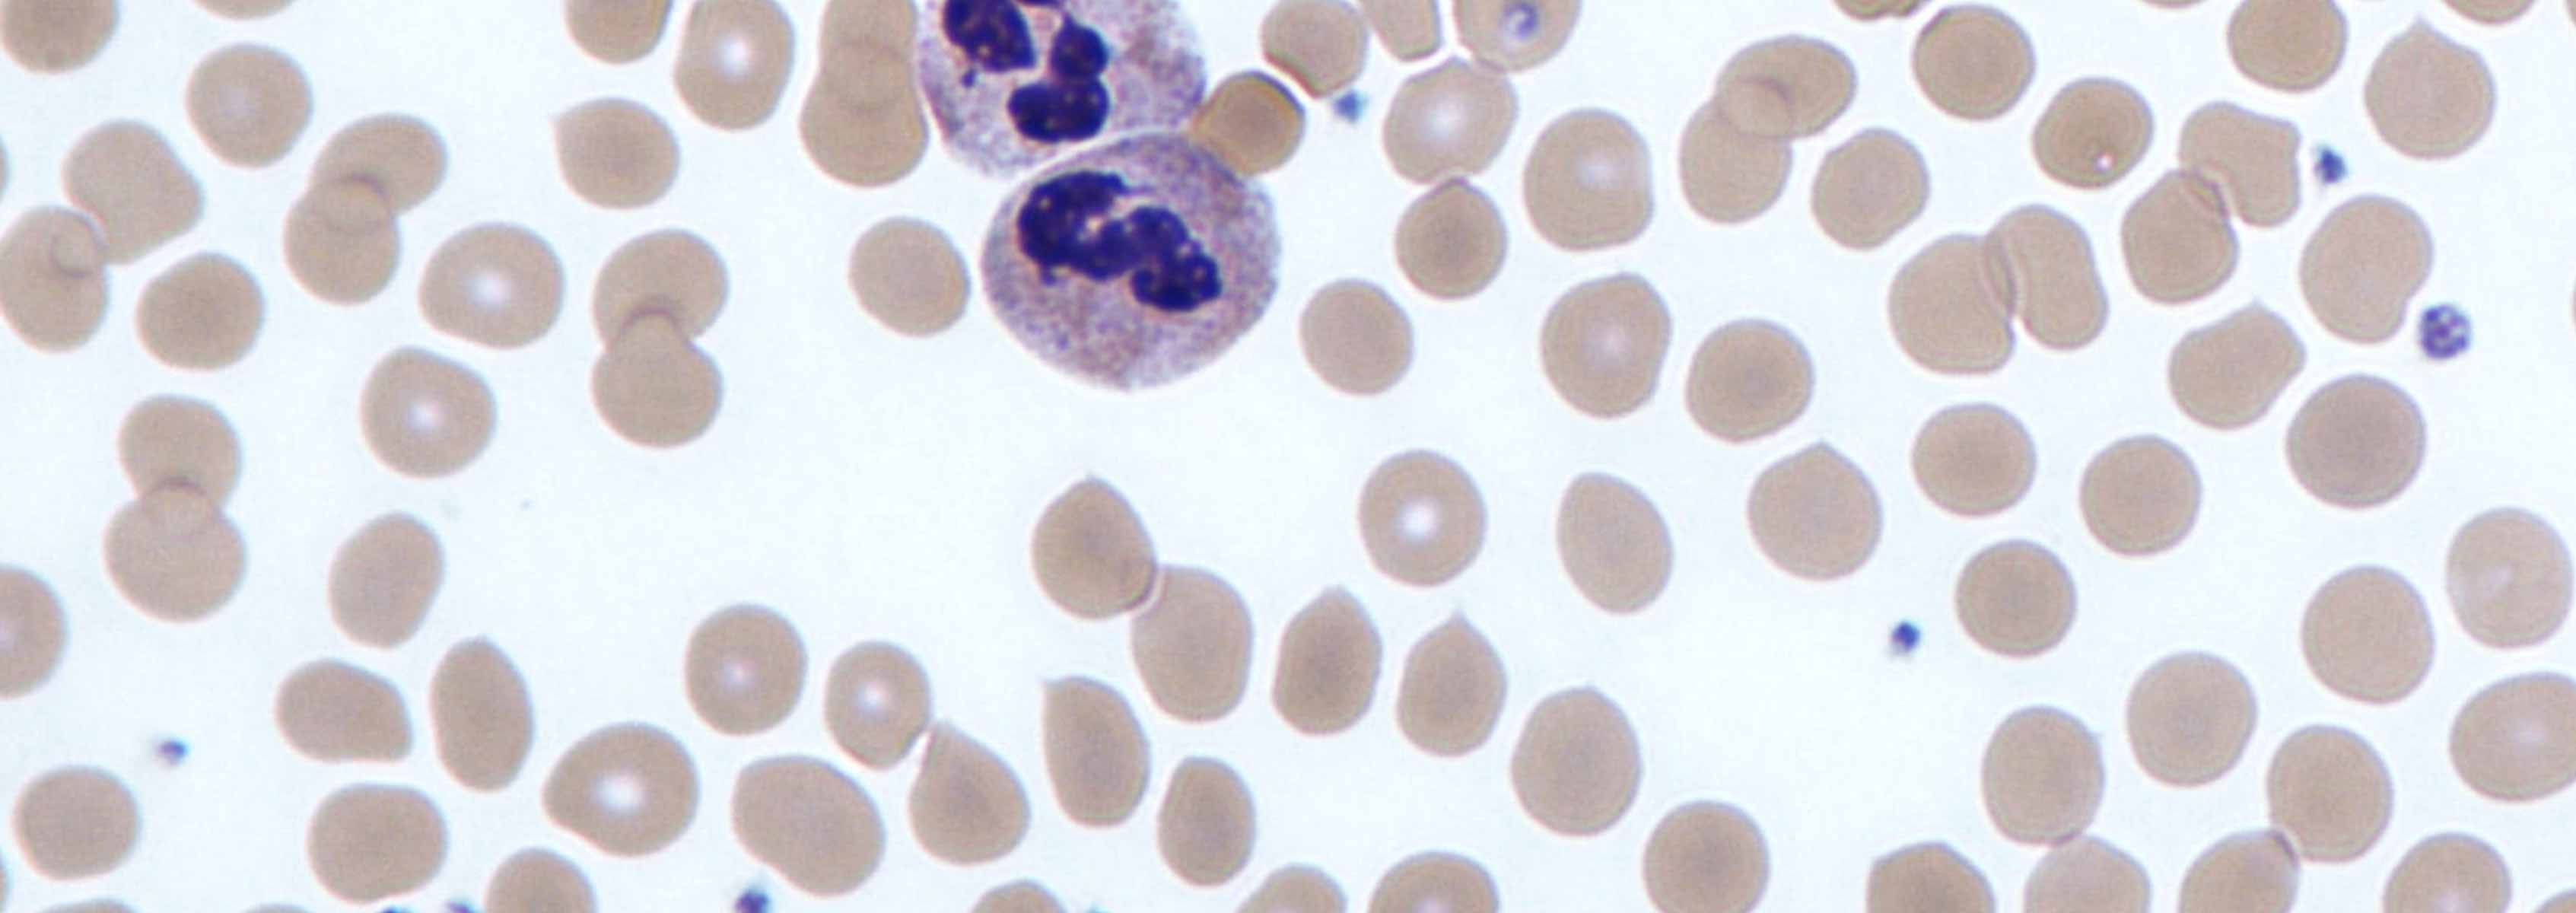

Diagnosis and Pathogenesis of Urinary Tract Infections
One hundred fifty million urinary tract infections (UTI) are estimated to occur worldwide each year causing significant morbidity in people. Little progress has been made to lower the incidence of UTIs and reduce the public health threat derived from multidrug-resistant UTI pathogens. Systems Biology tools may yield new insights into processes and new drug targets to prevent and treat UTIs effectively.
The investigator’s laboratory has developed scalable metaproteomic (LC-MS/MS) methods as a tool to diagnose urogenital infections using clinical samples. Data are generated on the infectious agents, the intensity of the patient’s immune response and, if applicable, the resident microbiome.
The investigator’s laboratory uses molecular and cellular biology methods as well as proteomics to characterize host-pathogen interactions in the urinary tract. Recently, we discovered that neutrophils release antibacterial effectors via degranulation into urine and form extracellular traps.